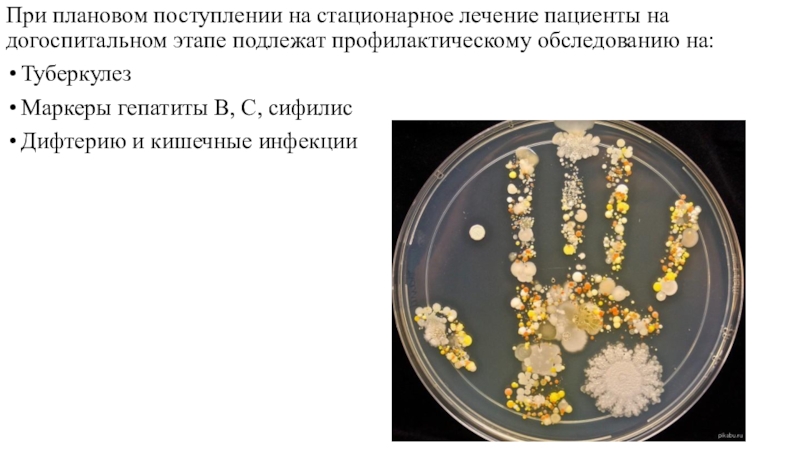

Разделы презентаций
- Разное
- Английский язык
- Астрономия
- Алгебра
- Биология
- География
- Геометрия
- Детские презентации
- Информатика
- История
- Литература
- Математика
- Медицина
- Менеджмент
- Музыка
- МХК
- Немецкий язык
- ОБЖ
- Обществознание
- Окружающий мир
- Педагогика
- Русский язык
- Технология
- Физика
- Философия
- Химия
- Шаблоны, картинки для презентаций
- Экология
- Экономика
- Юриспруденция
Режимы лечебно-профилактических учреждений
Содержание
- 1. Режимы лечебно-профилактических учреждений
- 2. Необходимые условия для пациентов в больнице обеспечивают 3 режима: Лечебно-охранительный Гигиенический Санитарно-эпидемиологический
- 3. Ⅰ. Лечебно-охранительный режим- это система организационных мероприятий
- 4. соблюдение времени врачебного обхода, выполнение лечебных процедур,
- 5. Посещение больных родственникамиОрганизация досуга ( шашки, шахматы, радио, чтение, рукоделие)
- 6. Высокая служебная дисциплина, внимание, тактичное и сочувственное
- 7. Физический комфорт : функциональные кровати, удобная постель,
- 8. В больнице недопустим шум!Больные реагируют на шум в среднем в 2 раза сильнее здоровых
- 9. Ⅱ. Гигиенический режим - это научно-обоснованная система правил, регулирующих надлежащие коммунальные условия в помещениях больниц.
- 10. Гигиенический режим обеспечивается созданием оптимального микроклимата, световым
- 11. Сохранение чистоты воздуха в больничных помещениях: обмен
- 12. Ультрафиолетовая радиация- мощный и быстродействующий бактерицидный агент
- 13. Методы применения УФ излучения: Прямое облучениеНепрямое облучение-
- 14. -Личная гигиена медицинского персонала: аккуратный, собранный и
- 15. Гигиенические условия являются важной предпосылкой предупреждения ВБИ
- 16. Ⅲ.Противоэпидемический режимЭто многоступенчатая система всех мероприятий,
- 17. Неспецифическая профилактика ВБИ: Архитектурно-планировочные и конструктивные решения
- 18. Специфическая профилактика ВБИПредусматривает плановую и экстренную, активную
- 19. При плановом поступлении на стационарное лечение пациенты
- 20. Спасибо За Внимание!!!
- 21. Скачать презентанцию
Необходимые условия для пациентов в больнице обеспечивают 3 режима: Лечебно-охранительный Гигиенический Санитарно-эпидемиологический
Слайды и текст этой презентации
Слайд 1Режимы лечебно-профилактических учреждений
«Терапия прежде всего- гигиена больного человека, она бессильна,
если не созданы необходимые для больного гигиенические условия»
Слайд 2Необходимые условия для пациентов в больнице обеспечивают 3 режима:
Лечебно-охранительный
Гигиенический
Санитарно-эпидемиологический
Слайд 3Ⅰ. Лечебно-охранительный режим
- это система организационных мероприятий и правил, направленных
на обеспечение физического и психического комфорта больных.
Слайд 4соблюдение времени врачебного обхода, выполнение лечебных процедур, раздачи лекарств, а
также организация питания и обеспечение условий для дневного сна
Слайд 5Посещение больных родственниками
Организация досуга ( шашки, шахматы, радио, чтение, рукоделие)
Слайд 6Высокая служебная дисциплина, внимание, тактичное и сочувственное отношение к личности
пациента
Возможность пребывания на свежем воздухе; лечебная физкультура и трудотерапия
Слайд 7Физический комфорт : функциональные кровати, удобная постель, оптимальное количество больных
и обеспечение их психологической совместимости. Заселение палат происходит с учётом
характера и течения заболевания, периода болезни, возраста больных.Психологический комфорт: эстетическое оформление помещений и рациональное освещение.
Слайд 9Ⅱ. Гигиенический режим
- это научно-обоснованная система правил, регулирующих надлежащие
коммунальные условия в помещениях больниц.
Слайд 10Гигиенический режим обеспечивается созданием оптимального микроклимата, световым комфортом, достаточным инсоляционным
режимом, санитарным содержанием помещений.
Для больных и медицинского персонала в больницах
должны быть созданы благоприятные условия для выполнения правил личной гигиеныСлайд 11Сохранение чистоты воздуха в больничных помещениях: обмен воздуха и борьба
с пылью.
Борьба с пылью:
Систематическая уборка помещений, сочетающейся с проветриванием их;
Систематическая чистка мягкого инвентаря на открытом воздухе;
фиксирование пыли путем покрытия полов и импрегнации халатов
Слайд 12Ультрафиолетовая радиация- мощный и быстродействующий бактерицидный агент при облучении воздуха
или поверхности различных предметов.
Источники: ртутно-кварцевые лампы высокого давления и бактерицидные
ультрафиолетовые лампы низкого давленияСлайд 13Методы применения УФ излучения:
Прямое облучение
Непрямое облучение- отражёнными лучами
Облучение приточного
воздуха в вентиляционных или циркуляционных устройствах
Облучение палат целесообразно производить
в осенне-зимнее время и ранней весной 3-4 раза в день по 1 часуСлайд 14-
Личная гигиена медицинского персонала: аккуратный, собранный и культурный внешний вид,
педантичное выполнение правил личной гигиены
Все сотрудники, поступающие на работу
в больницу, подлежат обязательному медицинскому осмотру В каждой больнице должна быть предусмотрена возможность принятия персоналом душа после работы
Слайд 15Гигиенические условия являются важной предпосылкой предупреждения ВБИ
Создание гигиенических условий
зависит от системы больничного строительства ( это к Лере Симахиной)
Слайд 16 Ⅲ.Противоэпидемический режим
Это многоступенчатая система всех мероприятий, направленных на предупреждение
ВБИ, возникающих у больных во время пребывания в стационаре
Ответственность
за организацию и проведение комплекса санитарно-гигиенических и противоэпидемических мероприятий в больнице возлагается на главного врача, а ответственность по профилактике ВБИ – на заведующего отделения Слайд 17Неспецифическая профилактика ВБИ:
Архитектурно-планировочные и конструктивные решения зданий и
помещений для медицинской деятельности должны обеспечивать оптимальные условия для осуществления
лечебно-диагностического процесса, соблюдения санитарно-противоэпидемического режима и труда медицинского персонала. Высота помещений допускается не менее 2,6 м.Организация рационального воздухообмена в основных помещениях больницы
Повышение санитарной культуры персонала и больных, разделение потоков больных, «чистых» и «грязных» материалов, выявление, санация и лечение бактерионосителей
Дезинфекционно-стерилизационные мероприятия